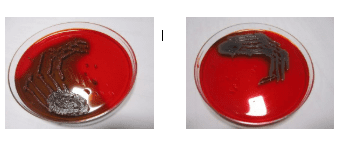

Abstract:
Background:
The phenomenon of antibacterial resistance has become a growing topic of issue the exploitation of antibacterial drugs on humans have resulted in the evolution of drug-resistant pathogens. Hence there is a need to determine the antibiofilm activity of Homoeopathic medicine Calendula officinalis.
Keywords: Calendula officinalis tincture, Antibiofilm, Antimicrobial resistance
Abbreviations:
Minimum Inhibitory Concentration (MIC), Minimum Biofilm Eradication Concentration (MBEC), Optical Density (OD), Mother tincture (Q)
Materials and Methods:
The study was carried out in Microbiological laboratory, Coimbatore, Tamil Nadu, where the MIC and MBEC is determined by measuring the OD of different amount of each of the given samples of Calendula officinalis Q, 30C, 200C.
Result:
Calendula officinalis tincture has exhibited good biofilm inhibitory and eradication effects than 30C and 200C. Later 200C has exhibited good inhibitory effects than 30C with respect to both the microorganisms tested.
Conclusion:
Homoeopathic medicine Calendula officinalis is primarily used to treat wounds, considering it is important to identify its antibiofilm properties because biofilm producing microorganisms become a hinderance in healing. Through this research it is identified that homoeopathic medicine calendula officinalis exhibits antibiofilm properties.
Introduction:
According to WHO the statistics reveal that antimicrobial resistance was directly responsible for 1.27 million global deaths in 2019. The global escalation of antibiotic resistance represents a critical danger as it compromises the efficacy of common antibiotics against widespread bacterial infections [1]. The 2022 Global Antimicrobial Resistance and Use Surveillance System (GLASS REPORT) [2] emphasizes upon the increasing resistant rates of prevalent bacterial pathogens.
Moreover, a study on antibacterial resistance on species isolated from wound infection has revealed that, most common species detected from wound was Staphylococcus aureus (79.4%) and Pseudomonas aeruginosa (40.2%), among which it was identified that both species showed increased resistance to Ampicillin, Gentamicin, Penicillin. Also, antibiotics are sometimes associated with unfavourable reactions in host such as hypersensitivity, immune suppression and allergic reactions [3]. The main reason for such a resistance to be manifested is because of biofilm formation.
Especially in case of open chronic wounds, Eg: in cases of long-standing ulcerations there are chances of establishment of biofilm which may hinder the process of healing, and the wound is said to be in a biofilm infected state [4]. Therefore, early prevention and appropriate treatment using effective antibiofilm agents is necessary.
Biofilm is a complex matrix of microorganisms, in which cells bind together and attach to biotic and abiotic surface. Chemical agents that infiltrate these matrixes are less effective because they act on unattached microorganism [5]. Recent increase in the interest of natural antimicrobial products have led to the identification of antibiofilm activity of many medicinal plants.
Calendula officinalis (Marigold) is used traditionally and homoeopathically as anti-inflammatory, antimicrobial, and antioxidant [6], but its antibiofilm activity has not been reported so far. As it is a plant extract, they appear as an alternative for typical antibiotics, therefore we see a need for this study to check the antibiofilm activity and contribute to the homoeopathic field of research.
Objectives of The Study:
- To study the in vitro antibiofilm activity of Calendula Officinalis Q in Staphylococcus aureus (gram +ve) and Pseudomonas aeruginosa (gram -ve) bacteria.To study the in vitro antibiofilm activity of Calendula Officinalis 30C in Staphylococcus aureus (gram +ve) and Pseudomonas aeruginosa (gram -ve) bacteria.
- To study the in vitro antibiofilm activity of Calendula Officinalis 200C in Staphylococcus aureus (gram +ve) and Pseudomonas aeruginosa (gram -ve) bacteria.
- To assess and evaluate the biofilm inhibition and biofilm eradication properties of calendula officinalis in various potencies
- Materials And Methods:
- Procurement of materials necessary:
- Homoeopathic medicine Calendula officinalis (Q,30C, & 200C) was procured from GMP certified government authorized homoeopathic pharmacy.
- The experiment was conducted in an ISO certified laboratory following all the lab safety measures and government rules.
- The bacteria culture was done according to laboratory rules.
- Methods:
- The individual bacterial culture that produces biofilm, respectively of Staphylococcus aureus and Pseudomonas aeruginosa was identified and isolated after which it was used to determine the Minimum Inhibitory Concentration (MIC) and Minimum Biofilm Eradication Concentration (MBEC).

Determination of Minimum Inhibitory Concentration (MIC):
ProcedureThe minimum inhibitory concentration (MIC) is determined by the inhibitory effects of the selected homoeopathic medicine, for which 96 well plate assay is used. The homoeopathic medicine is added separately at different volumes to determine the MIC. This process is done individually for Calendula officinalis tincture, 30C and 200C, and also in comparison to Staphylococcus aures and Pseudomonas aeruginosa separately. Ampicillin is used as a positive control and sterile saline is taken as a negative control. Then, these are incubated for 48 hours at 37ºC. The optical density of bacterial growth is measured by Elisa Microplate Reader (LISA SCAN EM) to assess the antibiofilm activity. MIC was also visually determined as the lowest concentration at which bacterial growth was not observed by using the reagent RESAZURIN to indicate colour difference.


Procedure
The minimum biofilm eradication is determined by using microorganisms that had already formed biofilm. Positive control used is Ampicillin and negative control is Sterile saline. The homoeopathic medicine was added separately at different volumes to determine the MBEC. This process was done individually for Calendula officinalis tincture, 30C and 200C, and also in comparison to Staphylococcus aures and Pseudomonas aeruginosa separately. The plates were then incubated overnight at 37 °C under static condition. The plates were stained with
CRYSTAL VIOLET and the optical density (OD) was determined using ELISA Microplate Reader (LISA SCAN EM).

Discussion:
- The MIC value of Calendula officinalis tincture against biofilm forming Staphylococcus aureus is 40 µg/ml.
- The MIC value of Calendula officinalis 30C against biofilm forming Staphylococcus aureus is 320 µg/ml.
- The MIC value of Calendula officinalis 200C against biofilm forming Staphylococcus aureus is 80 µg/ml.
- The MIC value of Calendula officinalis tincture against biofilm forming Pseudomonas aeruginosa is 40 µg/ml.
- The MIC value of Calendula officinalis 30C against biofilm forming Pseudomonas aeruginosa is 160 µg/ml.
- The MIC value of Calendula officinalis 200C against biofilm forming Pseudomonas aeruginosa is 80 µg/ml.
From these results it is proven that homoeopathic medicine calendula officinalis tincture has got the most effective antibiofilm inhibition activity against Staphylococcus aureus and Pseudomonas aeruginosa bacteria.

From this Graph 1 it is understood that the Minimum Inhibitory Concentration of Calendula officinalis mother tincture against biofilm producing Staphylococcus aureus and Pseudomonas aeruginosa bacteria is 40 µg/ml. Here Calendula officinalis mother tincture is given more importance as it has shown better results than Calendula officinalis 30C and Calendula officinalis 200C.
The minimum biofilm eradication concentration is established to be better by Calendula officinalis mother tincture and Calendula officinalis 200C at 1280 µg/ml than 30C in respect to both the microorganisms selected for the test.

From the above Graph 2 the eradication of staphylococcus aureus and pseudomonas aeruginosa has been the highest at 1280 µg/ml. The eradication has gradually increased with the increase in volume of Calendula officinalis used. Calendula officinalis tincture is found to be most effective in eradicating the biofilm than compared to Calendula officinalis 200C.
CONCLUSION:
It has been proved that homoeopathic medicine Calendula officinalis possesses antibiofilm activity also. Moreover, it is also proved that Calendula officinalis tincture and Calendula officinalis 200C is more effective in inhibiting the biofilm growth and also plays an efficient role in eradication of biofilm produced by Staphylococcus aureus and Pseudomonas aeruginosa.

REFERENCE
- World Health Organization. Antimicrobial Resistance [Internet]. World Health Organization. World Health Organization; 2023. Available from: https://www.who.int/news-room/fact-sheets/detail/antimicrobial-resistance
- World Health Organization. Global Antimicrobial Resistance and Use Surveillance System (GLASS) report: 2022 [Internet]. www.who.int. 2022. Available from: https://www.who.int/publications/i/item/9789240062702
- Puca V, Marulli RZ, Grande R, Vitale I, Niro A, Molinaro G, et al. Microbial Species Isolated from Infected Wounds and Antimicrobial Resistance Analysis: Data Emerging from a Three-Years Retrospective Study. Antibiotics [Internet]. 2021 Sep 24;10(10):1162. Available from: https://www.ncbi.nlm.nih.gov/pmc/articles/PMC8532735/
- Aakansha Giri Goswami, Basu S, Banerjee T, Vijay Kumar Shukla. Biofilm and wound healing: from bench to bedside. European Journal of Medical Research. 2023 Apr 25;28(1).
- Percival SL, McCarty SM, Lipsky B. Biofilms and Wounds: An Overview of the Evidence. Advances in Wound Care [Internet]. 2015 Jul;4(7):373–81. Available from: https://www.ncbi.nlm.nih.gov/pmc/articles/PMC4486148/
- Jyotisree G, Sruthi R, Biju C, Menon A. Year of Publication. Journal of Applied Pharmaceutical Research [Internet]. 2020 [cited 2021 Sep 27];8(2):8–12. Available from: https://media.neliti.com/media/publications/320117-calendula-officinalis-and-echinacae-purp-76806cf4.pdf
Dr. R.R. Karthikeyan 1,
Ms. Aparna Alagesan 2,
Dr. S. Rajkumar 3
- Deputy Medical Superintendent, Professor And Hod, Department Of Community Medicine, Rvs Homoeopathy Medical College And Hospital, Coimbatore, Tamilnadu.
Member- Expert Committee (Community Medicine, Research Methodology And Biostatistics) Homoeopathy Education board, national Commission For Homoeopathy.
- Student, Final Year Bhms, Rvs Homoeopathy Medical College And Hospital, Coimbatore, Tamilnadu
- Lab Head & Microbiologist, Micro Tech Diagnostic Centre, Coimbatore, Tamilnadu

